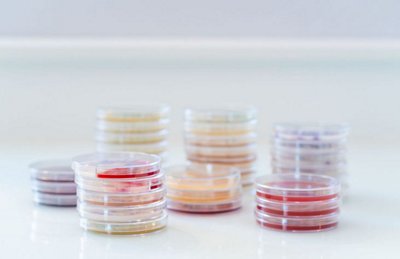

Culture Media for Food Applications
COMPREHENSIVE CONTROL
More than 60 years of experience on culture media and microbiology have lead bioMérieux to develop a large range of culture media to suit your daily needs & improve your lab's quality work.
Our methods demonstrate high efficiency and strong reliability.

- Overview
- Tests
- Resources
- Catalog
Product Details
We propose recognized culture media solutions for all kind of applications in food microbiology:
- For detection or numeration:
- bioMérieux is the reference method for Listeria (ALOA).
- Solutions for reference methods with a large scope of microorganisms are available : Salmonella, Listeria, Bacillus, Cronobacter, Campylobacter …
- For easier and cost-effective workflow : bioMérieux develops “bag and plate” solutions: alternative culture media methods (e.g. Bacara for Bacillus or Salma for Salmonella)
- For confirmation of alternative methods like GENE-UP®, VIDAS®, or other culture media methods.
Main Benefits
- Reliable and rapid results in 24 hours.
- Allow for streamlined workflow and increased productivity.
Features
- Easy to use protocols.
- High selectivity and specificity.
- Comprehensive range of chromogenic media.
- Internationally validated methods (AFNOR Certification – under the NF VALIDATION mark using the NF102 certification rules (available on the website https://nf-validation.afnor.org/en/) and AOAC).
- Different ready-to-use format available:
Plates
Tubes
Bottles
Bags
Tests
bioMérieux culture media are available in ready to use culture plates, tubes, bottles or bags and dehydrated powders (availability depending on countries and culture media type: contact us for more information).
The Quality Control Laboratory of Craponne manufacturing sites (France), is accredited by COFRAC in accordance with the international standard ISO / IEC 17025: 2017 for the realization of the control and performance of culture media - Ready to use solid and liquids according to standard NF EN ISO 11133 “Microbiology of food, animal feed and water — Preparation, production, storage and performance testing of culture media”.
These accreditations, together with all guarantees provided by bioMérieux, constitute the elements that can justify the simplification of performance testing at reception of our ready-to-use culture media.
Our portfolio of culture media solutions is designed for the detection of a wide range of food pathogens, including:
- Listeria monocytogenes
- Listeria spp
- Salmonella
- Campylobacter
- EHEC
- Bacillus cereus
- Cronobacter
- Vibrio
- E.coli 0157:H7
Accreditation Certificate Craponne - COFRAC 17025
Download
- Filename
- accreditation-Craponne--COFRAC-17025.pdf
- Size
- 441 KB
- Format
- application/pdf
Accreditation Certificate Combourg - COFRAC 17025
Download
- Filename
- accreditation-combourg---COFRAC-17025.pdf
- Size
- 435 KB
- Format
- application/pdf
Food Culture Media Solutions
Download
- Filename
- FOOD CULTURE MEDIA.pdf
- Size
- 6 MB
- Format
- application/pdf
ALOA® Detection, Enumeration and Confirmation of L. spp. and L. monocytogenes
Download
- Filename
- ALOA LISTERIA_1.pdf
- Size
- 1 MB
- Format
- application/pdf
CAMPYFOOD® Detection and Enumeration of Campylobacter
Download
- Filename
- CAMPYFOOD CAMPYLOBACTER_4.pdf
- Size
- 2 MB
- Format
- application/pdf
SALMA® Detection and Confirmation of Salmonella spp.
Download
- Filename
- SALMA SALMONELLA_1.pdf
- Size
- 10 MB
- Format
- application/pdf
BIOMERIEUX and DAIRY INDUSTRIES
Download
- Filename
- BIOMERIEUX and DAIRY INDUSTRIES.pdf
- Size
- 6 MB
- Format
- application/pdf
BIOMERIEUX and POULTRY INDUSTRIES
Download
- Filename
- BIOMERIEUX and POULTRY INDUSTRIES.pdf
- Size
- 4 MB
- Format
- application/pdf
BIOMERIEUX and BEEF INDUSTRIES
Download
- Filename
- BIOMERIEUX and BEEF INDUSTRIES.pdf
- Size
- 6 MB
- Format
- application/pdf
BIOMERIEUX and PROCESSED FOOD INDUSTRIES
Download
- Filename
- BIOMERIEUX and PROCESSED FOOD INDUSTRIES.pdf
- Size
- 5 MB
- Format
- application/pdf
CULTURE MEDIA VALIDATED METHODS LIST
Download
- Filename
- List-of-Validated-Methods---Culture-Media.pdf
- Size
- 43 KB
- Format
- application/pdf
Chromogenic Media
Salmonella spp.
Campylobacter spp.
STEC/EHEC
Enterobacteriaceae
Listeria spp, L.monocytogenes
Bacillus cereus









?qlt=85&ts=1777293151264&dpr=off)






